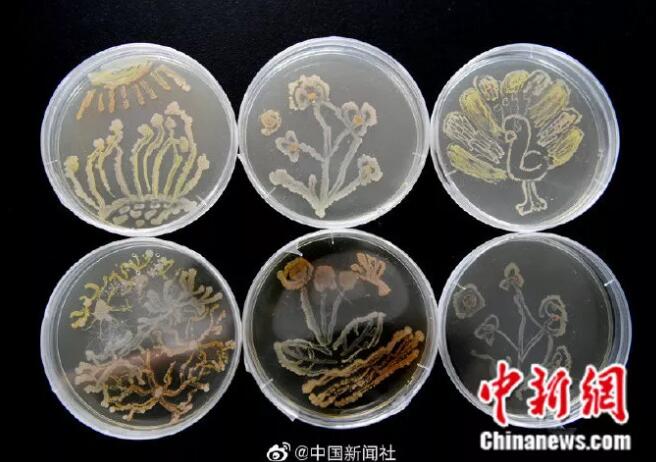

男友打撈落水女童她急救,他們有大學(xué)生最美的樣子!
大學(xué)生
一個(gè)富有青春、活力的名詞
大學(xué)生活
豐富多彩、千姿百態(tài)
什么是真正的大學(xué)生?
他們,有想法
從2017年9月起
哈爾濱師范大學(xué)的學(xué)生梁家進(jìn)
歷經(jīng)背包行、自駕、“摩旅”等多種方式
拍攝旅行電影
終于在2019年7月徹底完成作品

圖片來源:中新視頻截圖
“這一路來最大的收獲就是
知道了自己真正熱愛的是什么。
我想用鏡頭繼續(xù)記錄
生活的美好和大自然的神奇。”
他們,愛挑戰(zhàn)
2019年暑期學(xué)校一放假
大三學(xué)生周浩便從三亞出發(fā)
一路騎行萬里到達(dá)河北石家莊
途徑廣東、福建、江西、安徽等省份
算上2017、2018年暑假的騎行里程
周浩已自駕摩托車游歷中國28個(gè)省份
總行程近4萬公里
“我們不能擁有全世界,
但是我們可以去看遍全世界。”

他們,愛玩愛鬧,也愛創(chuàng)造
馬海龍是山西晉中的一名大學(xué)生
從小喜歡畫畫、建筑
高二時(shí)嘗試在游戲中建造自己的學(xué)校
耗時(shí)3年,母校的
操場、教學(xué)樓、科技樓、廣場等
均得到完美呈現(xiàn)

他們,有無限的想象與創(chuàng)造力
長春醫(yī)學(xué)高等專科學(xué)校的學(xué)生們
以空氣中的細(xì)菌為墨
以培養(yǎng)基為畫布
創(chuàng)作出一批“細(xì)菌畫”
繪畫完成后需在37℃恒溫條件下
培養(yǎng)24小時(shí)
形成菌苔后,“細(xì)菌畫”才會(huì)顯現(xiàn)
同學(xué)們介紹
這種不確定性讓細(xì)菌畫充滿魅力
他們,會(huì)在有需要時(shí)挺身而出
一對大學(xué)情侶在河邊散步時(shí)
聽見有人喊:“一位小姑娘落水了!”
男孩第一時(shí)間沖向前去
和路人一起將孩子打撈上來
而學(xué)護(hù)理的女友
當(dāng)即跪在地上對小姑娘做了心肺復(fù)蘇等
救人過程中,男孩的手機(jī)不慎丟失
但這對小情侶并沒有因此而感到沮喪
“一個(gè)手機(jī)算什么,
我們救的是一條人命!”

他們,有家庭的責(zé)任與擔(dān)當(dāng)
從大一開始
揚(yáng)州大學(xué)2016級學(xué)生李東明
就邊上學(xué)邊打工
每月給父母寄去生活費(fèi),挑起家庭重?fù)?dān)
今年上半年
照顧父母生活起居的姑姑去世
他將患有精神疾病的母親和殘疾父親
接到身邊照顧
“總是靠別人,
也總歸只能解決一時(shí)。”

他們,有時(shí)候會(huì)很“傻”
河南商丘工學(xué)院
大一女生小曲和室友在寢室就地取材
用被子、娃娃扮演獅子
臉盆衣服即興伴奏
在宿舍上演“舞獅”
“不在乎別人評論,
當(dāng)代大學(xué)生活就是要多姿多彩。”

他們,會(huì)共同進(jìn)步,共同成長
河北地質(zhì)大學(xué)資源學(xué)院的一個(gè)女生宿舍
全宿舍9名女生中
有8人考上
北京大學(xué)、中國地質(zhì)大學(xué)、中國科學(xué)院
等名校或國家重點(diǎn)科研機(jī)構(gòu)研究生

他們
是祖國的未來與希望
然而這些
僅僅是冰山一角……
一位網(wǎng)友表示
“上大學(xué)就輕松了。”是老師騙你的
“上了大學(xué)就能找對象了。”是媽媽騙你的
考試周之前沒日沒夜地學(xué)習(xí)
各種作業(yè),投票,活動(dòng)才是常態(tài)
宿舍,教室,食堂,圖書館
是最常出沒的地方
有時(shí)候也偷偷想家
然而即便是這樣
大學(xué)時(shí)光
仍然是最值得每個(gè)人懷念的
初時(shí)不經(jīng)意
一回頭
卻發(fā)現(xiàn)這是最好的時(shí)光
你的大學(xué)時(shí)光
是怎樣度過的?
還記得那些年
你的那些神奇室友嗎?
和小編分享你的大學(xué)經(jīng)歷
無奮斗,不青春!
來源:中國新聞社,綜合共青團(tuán)中央微信、中國新聞網(wǎng)、中新視頻、江蘇新聞、封面新聞
- 上一篇:這位老爺爺豆腐腦只賣1元拒漲價(jià)!原因太暖心…[ 11-19 ]
- 下一篇:沒有了!









